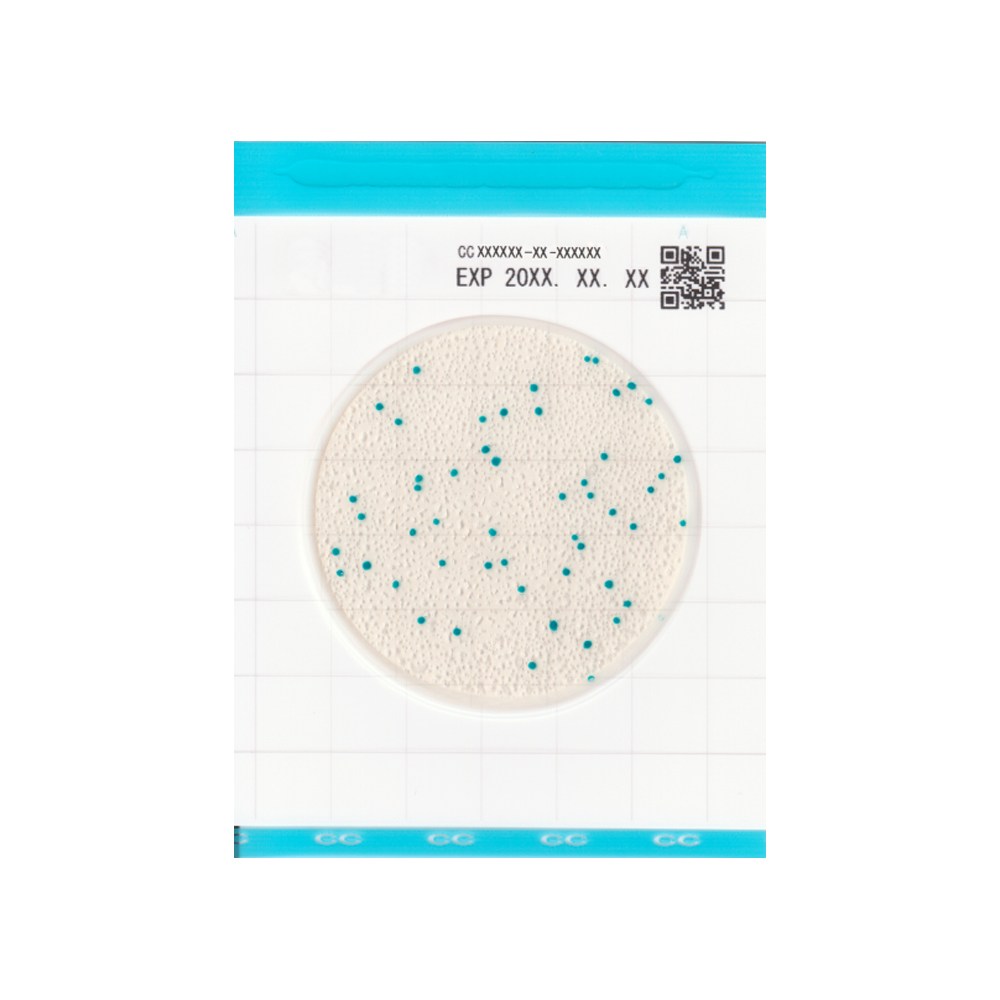
Kikkoman EasyPlate(Filmedia) 대장균군용 건조필름배지(CC) (25ea/pk) 29,700원

대장균 99.99% 제거 필터 무소음 도그케어 자동 급수기 강아지 고양이 반려동물 정수기, 정수기 DF03, 1개 가격 분석 리포트
2026년 4월 9일 기준, 이 상품의 가격은 39,000원입니다. roochas가 지난 4일간 추적한 데이터를 기준으로, 역대 최저가는 35,000원이며 현재가는 역대 최저가 대비 11% 높은 수준입니다. 평균 거래가 45,000원과 비교하면 약 6,000원(13%) 절약할 수 있습니다.
가격 변동성 분석
4일간 최저 35,000원에서 최고 45,000원까지, 가격 변동폭은 10,000원이며 변동률은 22%로 불안정 수준입니다. 최근 가격 추세는 상승세를 보이고 있습니다.
AI 구매 타이밍 판단
roochas AI가 분석한 현재 구매 타이밍은 “좋음”입니다. 평균가 대비 13% 저렴하며, 괜찮은 구매 기회로 판단됩니다. 실시간 가격 변동 알림을 통해 최적의 구매 시점을 놓치지 마세요.